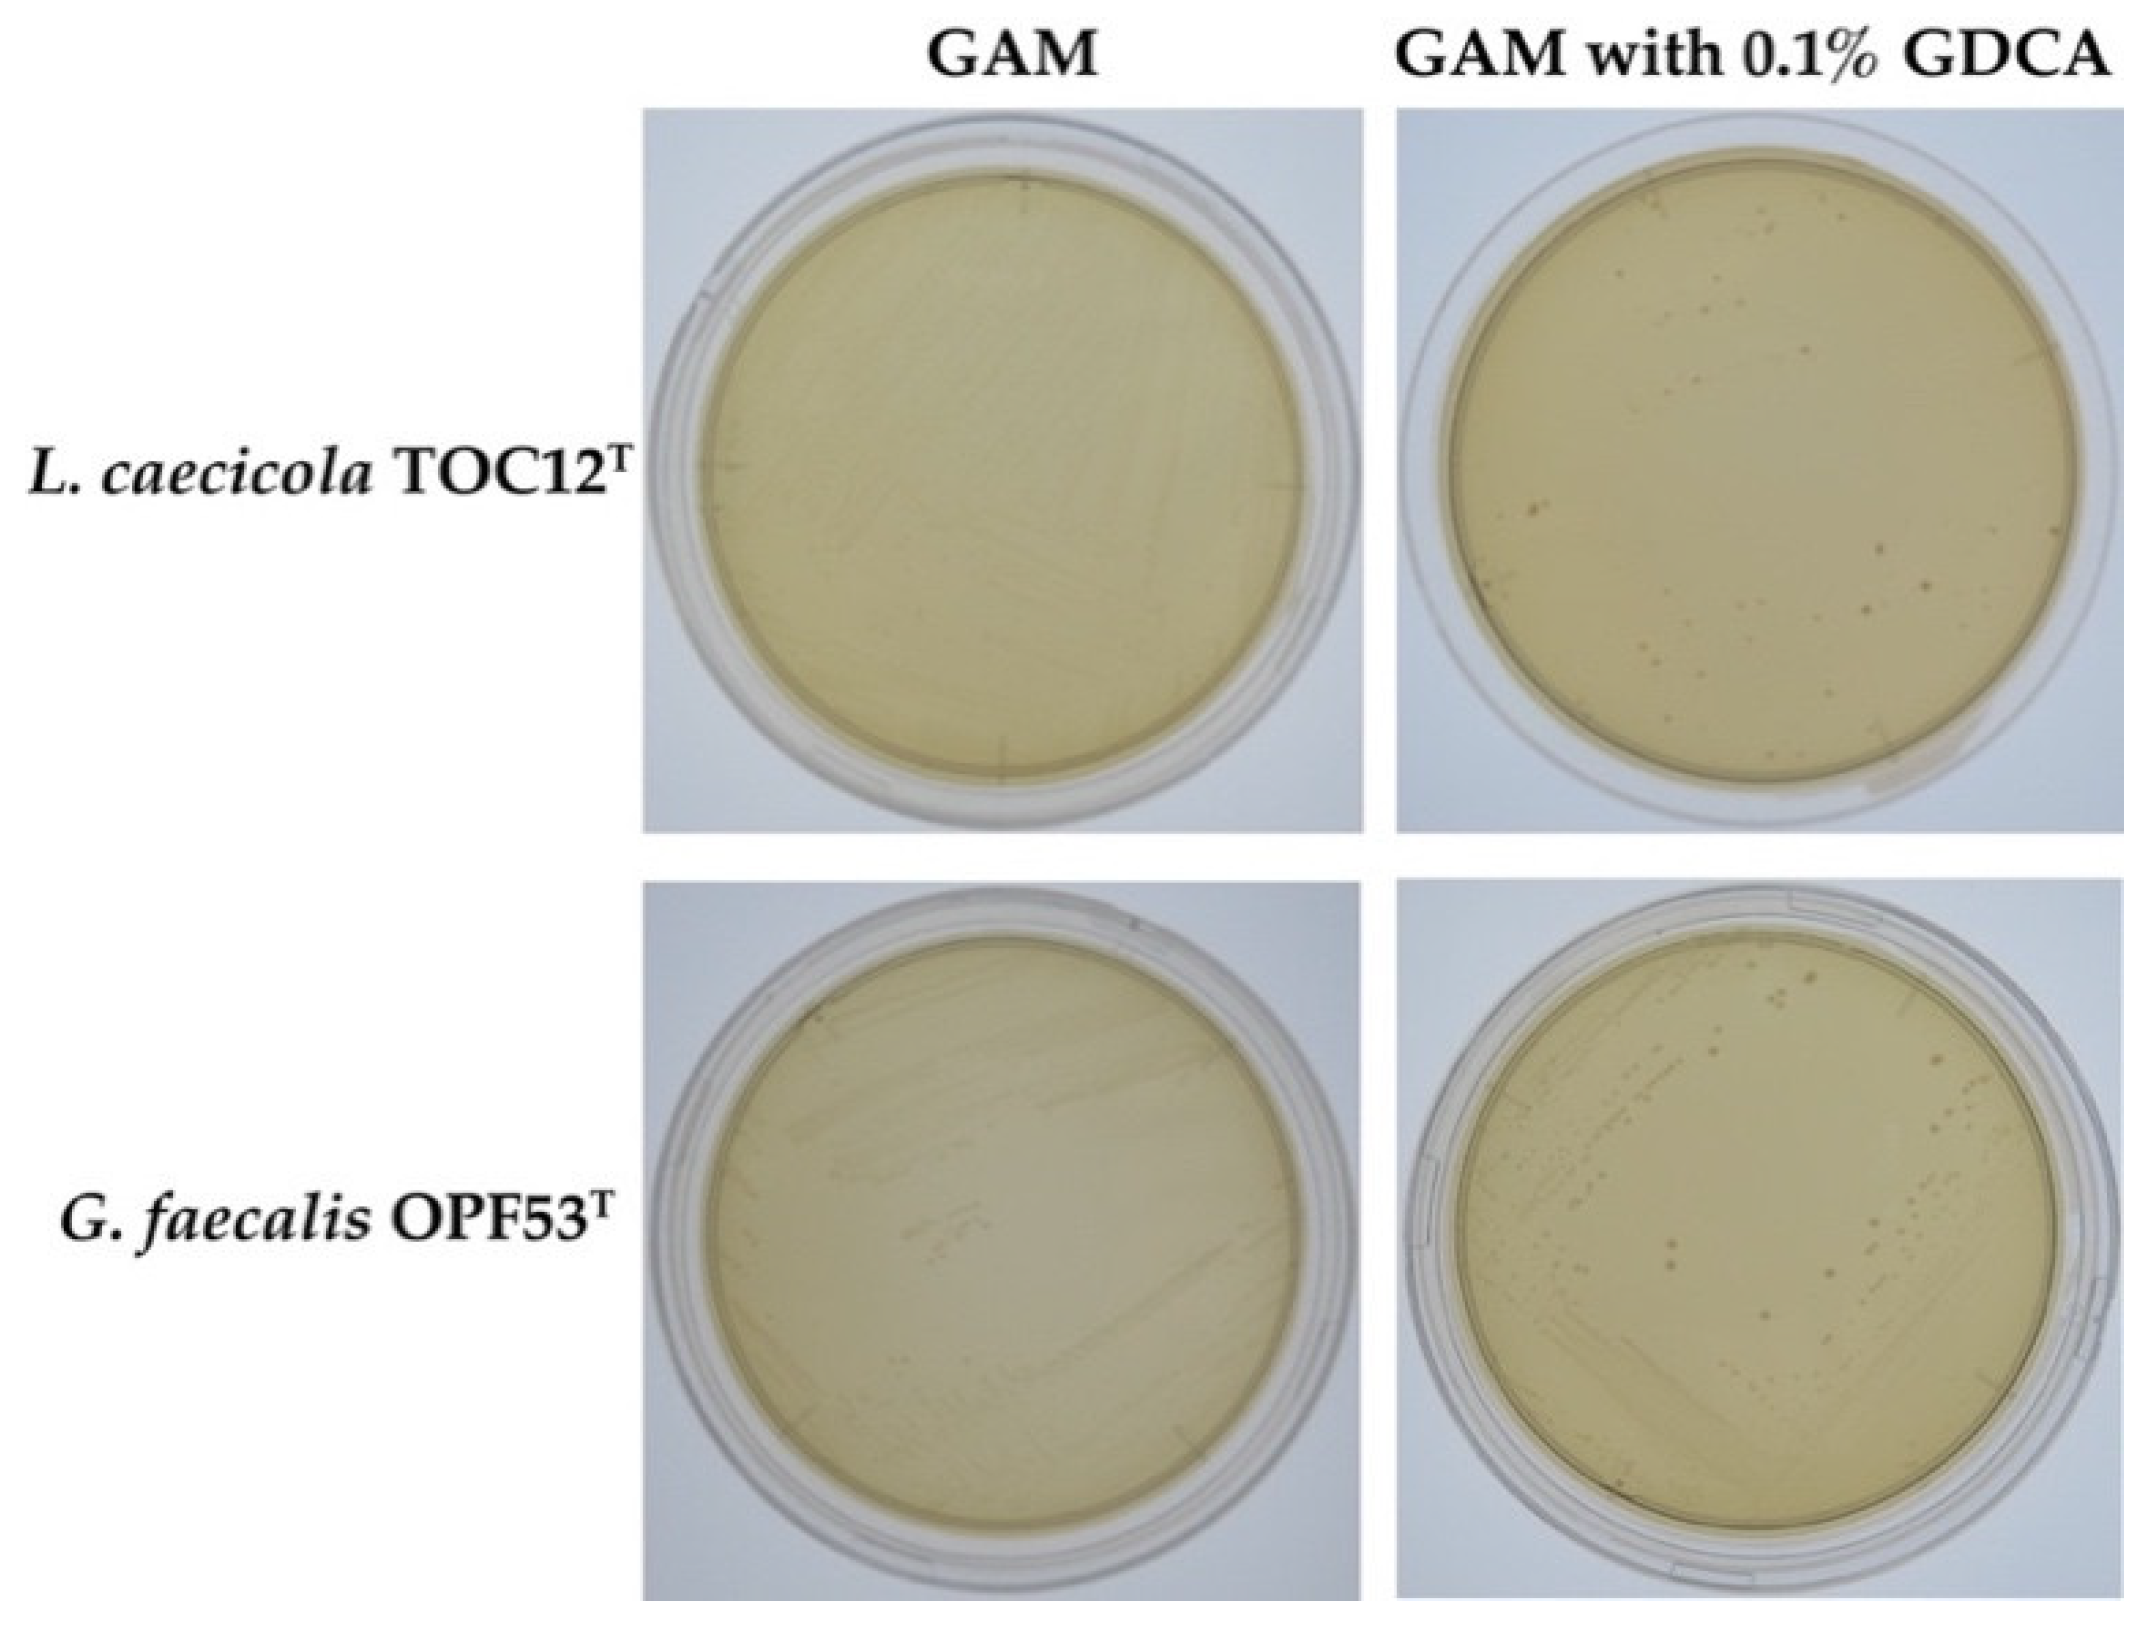
Ijms 23 10980 g001

Bile Salt Hydrolases with Extended Substrate Specificity Confer a High Level of Resistance to Bile Toxicity on Atopobiaceae Bacteria
Abstract
1. Introduction
2. Results and Discussion
2.1. Bile Resistance in L. caecicola TOC12T and G. faecalis OPF53T
2.2. Screening and Sequence Analyses of Putative BSH Genes
2.3. Enzymatic Activity of Heterologously Expressed LcBSH and GfBSH Proteins
2.4. Biochemical Characterization of LcBSH and GfBSH
2.5. Sequence Comparison and Phylogenetic Analyses
3. Materials and Methods
3.1. Bacterial Strains and Their Culture Conditions
3.2. Screening and Heterologous Expression of Putative Bile Salt Hydrolase (BSH) Genes
3.3. Sodium Dodecyl Sulfate Polyacrylamide Gel Electrophoresis (SDS-PAGE) Analysis
3.4. Enzymatic Activity
3.5. Biochemical Characterization
3.6. Bile Resistance Tests
3.7. Structural Modeling, Multiple Alignment, and Phylogenetic Analyses
4. Conclusions
Supplementary Materials
Author Contributions
Funding
Institutional Review Board Statement
Informed Consent Statement
Data Availability Statement
Conflicts of Interest
References
- Fuller, R. History and development of probiotics. In Probiotics; Springer: Berlin, Germany, 1992; pp. 1–8. [Google Scholar]
- Zommiti, M.; Feuilloley, M.G.J.; Connil, N. Update of Probiotics in Human World: A Nonstop Source of Benefactions till the End of Time. Microorganisms 2020, 8, 1907. [Google Scholar] [CrossRef] [PubMed]
- Kadooka, Y.; Sato, M.; Imaizumi, K.; Ogawa, A.; Ikuyama, K.; Akai, Y.; Okano, M.; Kagoshima, M.; Tsuchida, T. Regulation of abdominal adiposity by probiotics (Lactobacillus gasseri SBT2055) in adults with obese tendencies in a randomized controlled trial. Eur. J. Clin. Nutr. 2010, 64, 636–643. [Google Scholar] [CrossRef]
- Goldenberg, J.Z.; Lytvyn, L.; Steurich, J.; Parkin, P.; Mahant, S.; Johnston, B.C. Probiotics for the prevention of pediatric antibiotic-associated diarrhea. Cochrane Database Syst. Rev. 2015, CD004827. [Google Scholar] [CrossRef]
- Hertzler, S.R.; Clancy, S.M. Kefir improves lactose digestion and tolerance in adults with lactose maldigestion. J. Am. Diet. Assoc. 2003, 103, 582–587. [Google Scholar] [CrossRef]
- Bordoni, A.; Amaretti, A.; Leonardi, A.; Boschetti, E.; Danesi, F.; Matteuzzi, D.; Roncaglia, L.; Raimondi, S.; Rossi, M. Cholesterol-lowering probiotics: In vitro selection and in vivo testing of bifidobacteria. Appl. Microbiol. Biotechnol. 2013, 97, 8273–8281. [Google Scholar] [CrossRef]
- Dimidi, E.; Christodoulides, S.; Fragkos, K.C.; Scott, S.M.; Whelan, K. The effect of probiotics on functional constipation in adults: A systematic review and meta-analysis of randomized controlled trials. Am. J. Clin. Nutr. 2014, 100, 1075–1084. [Google Scholar] [CrossRef]
- de Melo Pereira, G.V.; de Oliveira Coelho, B.; Magalhaes Junior, A.I.; Thomaz-Soccol, V.; Soccol, C.R. How to select a probiotic? A review and update of methods and criteria. Biotechnol. Adv. 2018, 36, 2060–2076. [Google Scholar] [CrossRef]
- Psani, M.; Kotzekidou, P. Technological characteristics of yeast strains and their potential as starter adjuncts in Greek-style black olive fermentation. World J. Microbiol. Biotechnol. 2006, 22, 1329–1336. [Google Scholar] [CrossRef]
- Ogunremi, O.; Sanni, A.; Agrawal, R. Probiotic potentials of yeasts isolated from some cereal-based N igerian traditional fermented food products. J. Appl. Microbiol. 2015, 119, 797–808. [Google Scholar] [CrossRef] [PubMed]
- Foley, M.H.; O’Flaherty, S.; Barrangou, R.; Theriot, C.M. Bile salt hydrolases: Gatekeepers of bile acid metabolism and host-microbiome crosstalk in the gastrointestinal tract. PLoS Pathog. 2019, 15, e1007581. [Google Scholar] [CrossRef] [PubMed]
- Begley, M.; Hill, C.; Gahan, C.G. Bile salt hydrolase activity in probiotics. Appl. Environ. Microbiol. 2006, 72, 1729–1738. [Google Scholar] [CrossRef] [PubMed]
- Dong, Z.; Lee, B.H. Bile salt hydrolases: Structure and function, substrate preference, and inhibitor development. Protein Sci. 2018, 27, 1742–1754. [Google Scholar] [CrossRef] [PubMed]
- Bustos, A.Y.; Font de Valdez, G.; Fadda, S.; Taranto, M.P. New insights into bacterial bile resistance mechanisms: The role of bile salt hydrolase and its impact on human health. Food Res. Int. 2018, 112, 250–262. [Google Scholar] [CrossRef] [PubMed]
- Travers, M.A.; Sow, C.; Zirah, S.; Deregnaucourt, C.; Chaouch, S.; Queiroz, R.M.; Charneau, S.; Allain, T.; Florent, I.; Grellier, P. Deconjugated bile salts produced by extracellular bile-salt hydrolase-like activities from the probiotic Lactobacillus johnsonii La1 inhibit Giardia duodenalis in vitro growth. Front. Microbiol. 2016, 7, 1453. [Google Scholar] [CrossRef] [PubMed]
- Allain, T.; Chaouch, S.; Thomas, M.; Vallee, I.; Buret, A.G.; Langella, P.; Grellier, P.; Polack, B.; Bermudez-Humaran, L.G.; Florent, I. Bile-salt-hydrolases from the probiotic strain Lactobacillus johnsonii La1 mediate anti-giardial activity in vitro and in vivo. Front. Microbiol. 2018, 8, 2707. [Google Scholar] [CrossRef]
- Yoon, S.; Yu, J.; McDowell, A.; Kim, S.H.; You, H.J.; Ko, G. Bile salt hydrolase-mediated inhibitory effect of Bacteroides ovatus on growth of Clostridium difficile. J. Microbiol. 2017, 55, 892–899. [Google Scholar] [CrossRef]
- Coleman, J.P.; Hudson, L.L. Cloning and characterization of a conjugated bile acid hydrolase gene from Clostridium perfringens. Appl. Environ. Microbiol. 1995, 61, 2514–2520. [Google Scholar] [CrossRef]
- Dejean, G.; Tudela, H.; Bruno, L.; Kissi, D.; Rawadi, G.; Claus, S.P. Identifying a Novel Bile Salt Hydrolase from the Keystone Gut Bacterium Christensenella minuta. Microorganisms 2021, 9, 1252. [Google Scholar] [CrossRef]
- Chand, D.; Panigrahi, P.; Varshney, N.; Ramasamy, S.; Suresh, C.G. Structure and function of a highly active Bile Salt Hydrolase (BSH) from Enterococcus faecalis and post-translational processing of BSH enzymes. Biochim. Biophys. Acta Proteins Proteom. 2018, 1866, 507–518. [Google Scholar] [CrossRef]
- Kaya, Y.; Kök, M.Ş.; Öztürk, M. Molecular cloning, expression and characterization of bile salt hydrolase from Lactobacillus rhamnosus E9 strain. Food Biotechnol. 2017, 31, 128–140. [Google Scholar] [CrossRef]
- Ren, J.; Sun, K.; Wu, Z.; Yao, J.; Guo, B. All 4 Bile salt hydrolase proteins are responsible for the hydrolysis activity in Lactobacillus plantarum ST-III. J. Food Sci. 2011, 76, M622–M628. [Google Scholar] [CrossRef] [PubMed]
- Kusada, H.; Morinaga, K.; Tamaki, H. Identification of bile salt hydrolase and bile salt resistance in a probiotic bacterium Lactobacillus gasseri JCM1131T. Microorganisms 2021, 9, 1011. [Google Scholar] [CrossRef]
- Kusada, H.; Arita, M.; Tohno, M.; Tamaki, H. Isolation of a highly thermostable bile salt hydrolase with broad substrate specificity from Lactobacillus paragasseri. Front. Microbiol. 2022, 13, 810872. [Google Scholar] [CrossRef] [PubMed]
- Kusada, H.; Arita, M.; Tohno, M.; Tamaki, H. Bile salt hydrolase degrades β-lactam antibiotics and confers antibiotic resistance on Lactobacillus paragasseri. Front. Microbiol. 2022, 13, 858263. [Google Scholar] [CrossRef]
- Wang, Z.; Zeng, X.; Mo, Y.; Smith, K.; Guo, Y.; Lin, J. Identification and characterization of a bile salt hydrolase from Lactobacillus salivarius for development of novel alternatives to antibiotic growth promoters. Appl. Environ. Microbiol. 2012, 78, 8795–8802. [Google Scholar] [CrossRef] [PubMed]
- Sue, D.; Boor, K.J.; Wiedmann, M. σB-dependent expression patterns of compatible solute transporter genes opuCA and lmo1421 and the conjugated bile salt hydrolase gene bsh in Listeria monocytogenes. Microbiology 2003, 149, 3247–3256. [Google Scholar] [CrossRef]
- Daly, J.W.; Keely, S.J.; Gahan, C.G.M. Functional and phylogenetic diversity of BSH and PVA enzymes. Microorganisms 2021, 9, 732. [Google Scholar] [CrossRef]
- Binda, C.; Lopetuso, L.R.; Rizzatti, G.; Gibiino, G.; Cennamo, V.; Gasbarrini, A. Actinobacteria: A relevant minority for the maintenance of gut homeostasis. Dig. Liver Dis. 2018, 50, 421–428. [Google Scholar] [CrossRef]
- Kim, G.B.; Lee, B. Genetic analysis of a bile salt hydrolase in Bifidobacterium animalis subsp. lactis KL612. J. Appl. Microbiol. 2008, 105, 778–790. [Google Scholar] [CrossRef]
- Kim, G.B.; Brochet, M.; Lee, B.H. Cloning and characterization of a bile salt hydrolase (bsh) from Bifidobacterium adolescentis. Biotechnol. Lett. 2005, 27, 817–822. [Google Scholar] [CrossRef][Green Version]
- Kim, G.B.; Miyamoto, C.M.; Meighen, E.A.; Lee, B.H. Cloning and characterization of the bile salt hydrolase genes (bsh) from Bifidobacterium bifidum strains. Appl. Environ. Microbiol. 2004, 70, 5603–5612. [Google Scholar] [CrossRef] [PubMed]
- Tanaka, H.; Hashiba, H.; Kok, J.; Mierau, I. Bile salt hydrolase of Bifidobacterium longum-biochemical and genetic characterization. Appl. Environ. Microbiol. 2000, 66, 2502–2512. [Google Scholar] [CrossRef] [PubMed]
- Jarocki, P.; Targoński, Z. Genetic diversity of bile salt hydrolases among human intestinal bifidobacteria. Curr. Microbiol. 2013, 67, 286–292. [Google Scholar] [CrossRef] [PubMed]
- Zhao, X.; Zhou, S.; Yan, R.; Gong, C.; Gui, Q.; Zhang, Q.; Xiang, L.; Chen, L.; Wang, P.; Li, S.; et al. Parishin From Gastrodia Elata Ameliorates Aging Phenotype in Mice in a Gut Microbiota-Related Manner. Front. Microbiol. 2022, 13, 877099. [Google Scholar] [CrossRef] [PubMed]
- Ducarmon, Q.R.; Terveer, E.M.; Nooij, S.; Bloem, M.N.; Vendrik, K.E.W.; Caljouw, M.A.A.; Sanders, I.; van Dorp, S.M.; Wong, M.C.; Zwittink, R.D.; et al. Microbiota-associated risk factors for asymptomatic gut colonisation with multi-drug-resistant organisms in a Dutch nursing home. Genome Med. 2021, 13, 54. [Google Scholar] [CrossRef] [PubMed]
- Li, X.; Jensen, R.L.; Hojberg, O.; Canibe, N.; Jensen, B.B. Olsenella scatoligenes sp. nov., a 3-methylindole- (skatole) and 4-methylphenol- (p-cresol) producing bacterium isolated from pig faeces. Int. J. Syst. Evol. Microbiol. 2015, 65, 1227–1233. [Google Scholar] [CrossRef]
- Collins, M.D.; Wallbanks, S. Comparative sequence analyses of the 16S rRNA genes of Lactobacillus minutus, Lactobacillus rimae and Streptococcus parvulus: Proposal for the creation of a new genus Atopobium. FEMS Microbiol. Lett. 1992, 74, 235–240. [Google Scholar] [CrossRef]
- Olsen, I.; Johnson, J.L.; Moore, L.V.; Moore, W.E. Lactobacillus uli sp. nov. and Lactobacillus rimae sp. nov. from the human gingival crevice and emended descriptions of lactobacillus minutus and Streptococcus parvulus. Int. J. Syst. Bacteriol. 1991, 41, 261–266. [Google Scholar] [CrossRef]
- Selle, A.; Brosseau, C.; Dijk, W.; Duval, A.; Bouchaud, G.; Rousseaux, A.; Bruneau, A.; Cherbuy, C.; Mariadassou, M.; Cariou, V.; et al. Prebiotic Supplementation During Gestation Induces a Tolerogenic Environment and a Protective Microbiota in Offspring Mitigating Food Allergy. Front. Immunol. 2021, 12, 745535. [Google Scholar] [CrossRef]
- Sakamoto, M.; Iino, T.; Hamada, M.; Ohkuma, M. Parolsenella catena gen. nov., sp. nov., isolated from human faeces. Int. J. Syst. Evol. Microbiol. 2018, 68, 1165–1172. [Google Scholar] [CrossRef]
- Kraatz, M.; Wallace, R.J.; Svensson, L. Olsenella umbonata sp. nov., a microaerotolerant anaerobic lactic acid bacterium from the sheep rumen and pig jejunum, and emended descriptions of Olsenella, Olsenella uli and Olsenella profusa. Int. J. Syst. Evol. Microbiol. 2011, 61, 795–803. [Google Scholar] [CrossRef] [PubMed]
- Morinaga, K.; Kusada, H.; Sakamoto, S.; Murakami, T.; Toyoda, A.; Mori, K.; Meng, X.Y.; Takashino, M.; Murotomi, K.; Tamaki, H. Granulimonas faecalis gen. nov., sp. nov., and Leptogranulimonas caecicola gen. nov., sp. nov., novel lactate-producing Atopobiaceae bacteria isolated from mouse intestines, and an emended description of the family Atopobiaceae. Int. J. Syst. Evol. Microbiol. 2022; in press. [Google Scholar]
- Ammor, S.; Tauveron, G.; Dufour, E.; Chevallier, I. Antibacterial activity of lactic acid bacteria against spoilage and pathogenic bacteria isolated from the same meat small-scale facility: 1—Screening and characterization of the antibacterial compounds. Food Control 2006, 17, 454–461. [Google Scholar] [CrossRef]
- Fayol-Messaoudi, D.; Berger, C.N.; Coconnier-Polter, M.H.; Lievin-Le Moal, V.; Servin, A.L. pH-, Lactic acid-, and non-lactic acid-dependent activities of probiotic Lactobacilli against Salmonella enterica Serovar Typhimurium. Appl. Environ. Microbiol. 2005, 71, 6008–6013. [Google Scholar] [CrossRef] [PubMed]
- Hutt, P.; Shchepetova, J.; Loivukene, K.; Kullisaar, T.; Mikelsaar, M. Antagonistic activity of probiotic lactobacilli and bifidobacteria against entero- and uropathogens. J. Appl. Microbiol. 2006, 100, 1324–1332. [Google Scholar] [CrossRef] [PubMed]
- Prasad, J.; Gill, H.; Smart, J.; Gopal, P.K. Selection and characterisation of Lactobacillus and Bifidobacterium strains for use as probiotics. Int. Dairy J. 1998, 8, 993–1002. [Google Scholar] [CrossRef]
- Watanabe, S.; Tsuneyama, K. Cattle bile but not bear bile or pig bile induces lipid profile changes and fatty liver injury in mice: Mediation by cholic acid. J. Toxicol. Sci. 2012, 37, 105–121. [Google Scholar] [CrossRef][Green Version]
- Allain, T.; Chaouch, S.; Thomas, M.; Travers, M.A.; Valle, I.; Langella, P.; Grellier, P.; Polack, B.; Florent, I.; Bermudez-Humaran, L.G. Bile salt hydrolase activities: A novel target to screen anti-Giardia Lactobacilli? Front. Microbiol. 2018, 9, 89. [Google Scholar] [CrossRef]
- Rossocha, M.; Schultz-Heienbrok, R.; von Moeller, H.; Coleman, J.P.; Saenger, W. Conjugated bile acid hydrolase is a tetrameric N-terminal thiol hydrolase with specific recognition of its cholyl but not of its tauryl product. Biochemistry 2005, 44, 5739–5748. [Google Scholar] [CrossRef]
- Kim, G.B.; Yi, S.H.; Lee, B.H. Purification and characterization of three different types of bile salt hydrolases from Bifidobacterium strains. J. Dairy Sci. 2004, 87, 258–266. [Google Scholar] [CrossRef]
- Kumar, S.; Stecher, G.; Li, M.; Knyaz, C.; Tamura, K. MEGA X: Molecular evolutionary genetics analysis across computing platforms. Mol. Biol. Evol. 2018, 35, 1547–1549. [Google Scholar] [CrossRef] [PubMed]
- Letunic, I.; Bork, P. Interactive Tree Of Life (iTOL) v4: Recent updates and new developments. Nucleic Acids Res. 2019, 47, W256–W259. [Google Scholar] [CrossRef] [PubMed]
- Kusada, H.; Tamaki, H.; Kamagata, Y.; Hanada, S.; Kimura, N. A novel quorum-quenching N-acylhomoserine lactone acylase from Acidovorax sp. strain MR-S7 mediates antibiotic resistance. Appl. Environ. Microbiol. 2017, 83, e00080-17. [Google Scholar] [CrossRef] [PubMed]
- Rani, R.P.; Anandharaj, M.; Ravindran, A.D. Characterization of bile salt hydrolase from Lactobacillus gasseri FR4 and demonstration of its substrate specificity and inhibitory mechanism using molecular docking analysis. Front. Microbiol. 2017, 8, 1004. [Google Scholar] [CrossRef]
- Begley, M.; Gahan, C.G.; Hill, C. Bile stress response in Listeria monocytogenes LO28: Adaptation, cross-protection, and identification of genetic loci involved in bile resistance. Appl. Environ. Microbiol. 2002, 68, 6005–6012. [Google Scholar] [CrossRef]
- Waterhouse, A.; Bertoni, M.; Bienert, S.; Studer, G.; Tauriello, G.; Gumienny, R.; Heer, F.T.; de Beer, T.A.P.; Rempfer, C.; Bordoli, L. SWISS-MODEL: Homology modelling of protein structures and complexes. Nucleic Acids Res. 2018, 46, W296–W303. [Google Scholar] [CrossRef]
- Kumar, R.S.; Brannigan, J.A.; Prabhune, A.A.; Pundle, A.V.; Dodson, G.G.; Dodson, E.J.; Suresh, C.G. Structural and functional analysis of a conjugated bile salt hydrolase from Bifidobacterium longum reveals an evolutionary relationship with penicillin V acylase. J. Biol. Chem. 2006, 281, 32516–32525. [Google Scholar] [CrossRef]
- Pettersen, E.F.; Goddard, T.D.; Huang, C.C.; Couch, G.S.; Greenblatt, D.M.; Meng, E.C.; Ferrin, T.E. UCSF Chimera—A visualization system for exploratory research and analysis. J. Comput. Chem. 2004, 25, 1605–1612. [Google Scholar] [CrossRef]

| Strain | Minimum Inhibitory Concentrations (%) | |
|---|---|---|
| Bile Extracts | ||
| Cow Bile (Difco) | Porcine Bile (Sigma) | |
| L. caecicola TOC12T | 4.0 | 4.0 |
| G. faecalis OPF53T | 4.0 | 0.1 |
Publisher’s Note: MDPI stays neutral with regard to jurisdictional claims in published maps and institutional affiliations. |
© 2022 by the authors. Licensee MDPI, Basel, Switzerland. This article is an open access article distributed under the terms and conditions of the Creative Commons Attribution (CC BY) license (https://creativecommons.org/licenses/by/4.0/).
Share and Cite
Morinaga, K.; Kusada, H.; Tamaki, H. Bile Salt Hydrolases with Extended Substrate Specificity Confer a High Level of Resistance to Bile Toxicity on Atopobiaceae Bacteria. Int. J. Mol. Sci. 2022, 23, 10980. https://doi.org/10.3390/ijms231810980
Morinaga K, Kusada H, Tamaki H. Bile Salt Hydrolases with Extended Substrate Specificity Confer a High Level of Resistance to Bile Toxicity on Atopobiaceae Bacteria. International Journal of Molecular Sciences. 2022; 23(18):10980. https://doi.org/10.3390/ijms231810980
Chicago/Turabian StyleMorinaga, Kana, Hiroyuki Kusada, and Hideyuki Tamaki. 2022. "Bile Salt Hydrolases with Extended Substrate Specificity Confer a High Level of Resistance to Bile Toxicity on Atopobiaceae Bacteria" International Journal of Molecular Sciences 23, no. 18: 10980. https://doi.org/10.3390/ijms231810980
APA StyleMorinaga, K., Kusada, H., & Tamaki, H. (2022). Bile Salt Hydrolases with Extended Substrate Specificity Confer a High Level of Resistance to Bile Toxicity on Atopobiaceae Bacteria. International Journal of Molecular Sciences, 23(18), 10980. https://doi.org/10.3390/ijms231810980
